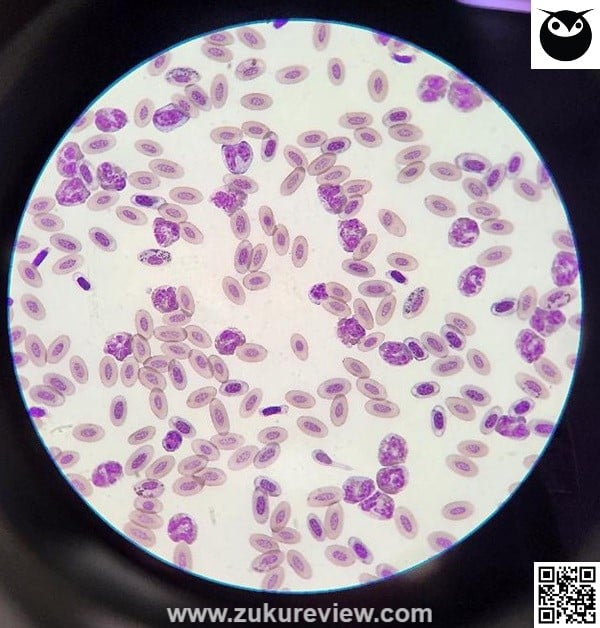
9608 101

Tuesday, February 17
Question of the Day
An adult bobwhite quail that is part of a backyard flock presents for lethargy and anorexia. Bloodwork reveals anemia and a blood smear is shown below.
What is the best way to definitively diagnose this bird’s condition?
